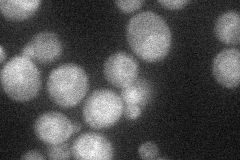
YLR092W
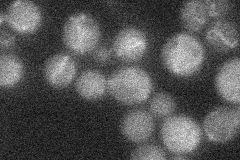
YLR092W
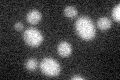
YLR092W

View description
High affinity sulfate permease; sulfate uptake is mediated by specific sulfate transporters Sul1p and Sul2p, which control the concentration of endogenous activated sulfate intermediates
Localization:
Intensity:
Fold change:
Significance:
-
C’ GFP library in SD

cytosol19.49 -
N' NOP1pr-GFP in SD
ambiguous23.4293 -
N' TEF2pr-mCherry in SD

vacuole9.77315 -
N' NATIVEpr-GFP in SD
below threshold16.4535 -
N' TEF2pr-VC and Cyto-VN in SD

below threshold25.2892 -
C’ GFP library in SD+DTT
cytosol13.710.7No -
C’ GFP library in SD+H2O2

cytosol16.830.86No -
C’ GFP library in Starvation Media

cytosol24.711.26No -
C’ GFP library on the background of Pup2-DaMP

cytosol -
C’ GFP library on the background of CCT mutant

cytosol16.03070.82216No
